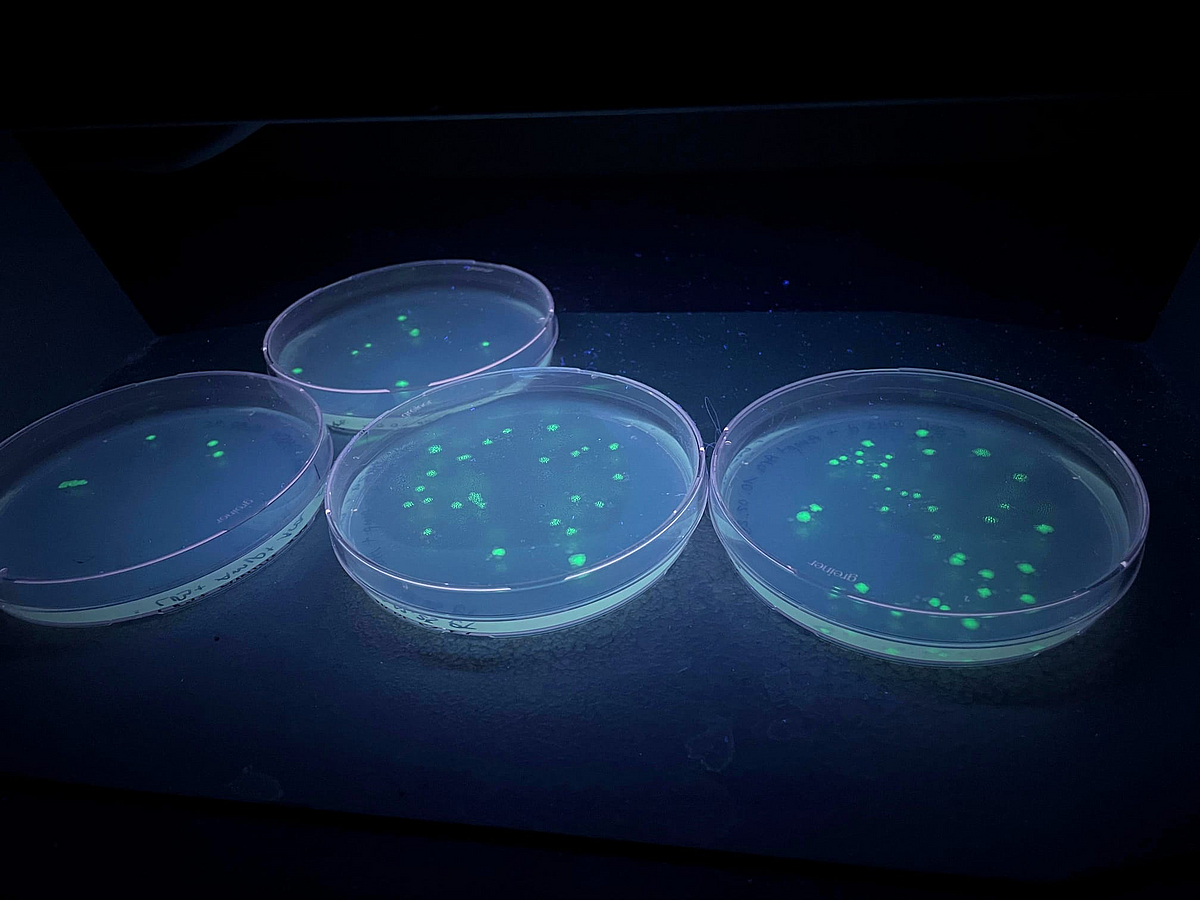

News und Einblicke
Laborpraktikum: Fluoreszierende Bakterien
In den letzten Wochen haben unsere Azubis zu Chemie- / Biologielaborant:innen während ihres Laborpraktikums wieder spannende Experimente durchgeführt!
Im ersten Versuch, den wir mit euch teilen möchten, haben die Azubis zu Biologielaborant:innen Bakterien genetisch so verändert, dass sie grün fluoreszieren - also leuchten, wenn sie mit einem bestimmten Zucker in Kontakt kommen. Um Verunreinigungen zu vermeiden und ein optimales Ergebnis zu erzielen, mussten einige Arbeitsschritte an der Sterilbank durchgeführt werden. Auf dem letzten Bild seht ihr den Vergleich zwischen den grün fluoreszierenden Bakterien rechts und den nicht fluoreszierenden Bakterien links. Durch den spannenden Versuch haben unsere Azubis ihr theoretisches Wissen über Gentechnik in die Praxis umgesetzt und dabei wichtige Labortechniken erlernt. Verfahren wie diese werden in einer Vielzahl von Arbeitsbereichen eingesetzt - von der medizinischen Forschung bis zur industriellen Produktion.

Bei diesem Versuch muss an der Sterilbank gearbeitet werden.
Die Bakterien fluoreszieren.


Hier sieht man links nicht fluoreszierende Bakterien neben fluoreszierenden Bakterien rechts.
Unsere Azubi-Campustour!
Am 03.02.2025 fand wieder unsere Azubi-Campustour statt! Gemeinsam haben wir das Zentrum für angewandte Raumfahrttechnologie und Mikrogravitation (ZARM), das MARUM, also das Zentrum für Marine Umweltwissenschaften, und das Deutsche Forschungszentrum für künstliche Intelligenz (DFKI) besucht! Anschließend ging es dann zu einem gemeinsamen Mittagessen in die Mensa.
Im ZARM konnten wir uns den einzigartigen Fallturm von Innen anschauen! Für einen Experimentendurchlauf wird dort mit 18 Pumpen ein Vakuum erzeugt, sodass die Experimente beim Fall aus 120 Metern Höhe der Schwerelosigkeit für ca. 5 Sekunden ausgesetzt werden. Durch das Katapult im Fallraum, welches sich in einem 10 m tiefen Schacht befindet, können sogar ca. 10 Sekunden Schwerelosigkeit erreicht werden.
Im MARUM wurde uns gezeigt, wie die Wissenschafler:innen den Ozeanboden erforschen. Mit Bohrgeräten konnte bereits eine Gesamtlänge von 192,4 km Bohrkernmaterial gesammelt werden. Dass an einem Bohrkern die (Klima-)geschichte des Ozeans abgelesen werden kann, wurde uns anhand eines Bohrkerns gezeigt, der das außerirdische Material Iridiumgestein enthält. Tatsächlich konnte an diesem Bohrkern der Meteoriteneinschlag, der die Dinosaurier ausgelöscht hat, abgelesen werden. Auch Tauchroboter und ein Sonar, das für die Kartierung des Meeresbodens zuständig ist, konnten wir uns anschauen.
Im DFKI haben wir dann die amtierenden Weltmeister des Robo-Fußballs kennengelernt. Während dem 1 gegen 1 der Roboter hat das menschliche Team uns erklärt, was alles passieren muss, damit die Roboter den Ball auf dem Platz finden und dann auch noch ins Tor schießen können. Nachdem wir das Team mit unseren vielen Fragen löchern durften, war die Institustführung schon wieder vorbei und es ging in die Mensa zum Mittagessen.
Herzlichen Dank an die Institute für die super spannenden Einblicke! Und natürlich auch an unsere Azubis Gabi und Stine für das Organisieren!









up2date. in der Tischlerei
Was passiert eigentlich in der Tischlerei? Diese Frage hat sich letztes Jahr up2date., das Online Magazin der Uni Bremen gestellt und Tischlermeisterin Christiane Sarnow und ihr Team an ihrem Arbeitsplatz besucht.
Neben zwei Gesell:innen arbeiten auch vier Auszubildende zur / zum Tischler:in in der Tischlerei. Ihre Aufgaben sind vielfältig: Die Herstellung, Montage und Reparatur von Möbeln, Treppen, Wänden, Böden und vielem mehr gehören genauso zu den To-dos wie Materialkauf, Kundenberatung und das Bedienen von Maschinen und Geräten.
Dabei ist der Tischlermeisterin Christiane Sarnow besonders wichtig, dass die Azubis die Theorie in der Tischlerei direkt praktisch umsetzen, sodass sie schnell selbstsicher und eigenverantwortlich ihre Arbeiten anfertigen können.
Seid ihr neugierig, was unsere Azubis über ihre Ausbildung in der Tischlerei berichtet haben? Den ganzen Artikel findet ihr unter up2date.uni-bremen.de/artikel/kennt-ihr-schon-die-tischlerei
Lars' Einblick in die IT
Hochkomplexe mathematische Berechnungen benötigen leistungsstarke Server! Und diese müssen regelmäßig gesichert werden. Denn ein Server, der täglich tausende Daten verarbeitet, ist nur so zuverlässig wie das Backup dahinter.
Lars ist im 2. Lehrjahr in der Ausbildung zum Fachinformatiker für Systemintegration und ist für die Funktionsfähigkeit der IT-Systeme der Industriemathematiker:innen an der Uni Bremen verantwortlich. Eine Aufgabe ist das Erstellen von Backups der von den Industriemathematiker:innen benutzten Server (2. Bild) auf einen Backup Server. Besonders schätzt Lars, dass er durch diese Tätigkeit Verantwortung übernehmen und aktiv zur Sicherheit der IT-Infrastruktur beitragen kann.
Vielen Dank für deinen Einblick!


Ein Netzteil wird gebaut
Einblicke in die Ausbildung zur/zum Elektroniker:in für Betriebstechnik
Auf unsere Azubis zur/zum Elektroniker*in für Betriebstechnik im zweiten Lehrjahr hat in den letzten Wochen eine ganz besondere Aufgabe gewartet: Sie haben ihr eigenes Netzgerät gebaut! Neben der richtigen (Schalt-)Planung und dem Bau des Gehäuses, ging es natürlich auch um die korrekte Verkabelung. Dabei wurden die einzelnen Schritte von unseren Azubis genau vorbereitet und allein durchgeführt.Ein wichtiges Teil jedes elektronischen Geräts ist die Platine. Auch diese haben unsere Azubis selbst angefertigt. Nachdem sie am Computer den Platinenplan entworfen haben, wurden alle einzelnen Bauelemente platziert und auf der Rückseite verlötet.
So wird Theorie zur Praxis - und genau das macht die Ausbildung spannend und abwechslungsreich! Ein großes Dankeschön an unsere Azubis für die spannenden Einblicke in eure Arbeit!




Gabis Auslandspraktikum
Ein Auslandspraktikum während der Ausbildung? Na klar, das geht! Unsere Auszubildende zur Veranstaltungskauffrau Gabi befindet sich zur Zeit in ihrem Auslandspraktikum auf Malta und hat sich die Zeit genommen, ihre Eindrücke mit uns zu teilen:
„Mein Praktikum auf Malta dauert drei Wochen und ermöglicht es mir, in einer Firma zu arbeiten, die mit meinem Berufsfeld als Veranstaltungskauffrau verbunden ist. Zu meinen Aufgaben in der Firma gehören Tätigkeiten wie Recherchen, Ideensammlungen zur Gestaltung zukünftiger Events sowie die Besichtigung lokaler Veranstaltungsorte. Vor Ort sorgt die Partnerfirma für unsere Betreuung, und wir können uns bei allen Fragen an sie wenden.
In der Freizeit bietet Malta beeindruckende Ausflugsziele. So haben wir bereits die historische Stadt Valetta erkundet, die frühere Hauptstadt Mdina mit ihrer wunderschönen Architektur besucht und die traumhafte Blaue Lagune entdeckt. Malta bietet eine bunte Mischung an Aktivitäten: von Schwimmen im Mittelmeer über Wanderungen zu den Dingli Cliffs bis hin zum Erkunden der kulturellen Museen der Insel!"
Liebe Gabi, viel Spaß weiterhin bei deinem Praktikum und vielen Dank für deine Eindrücke und Bilder.

Für Gabi ist das Praktikum auf Malta eine tolle Möglichkeit, Auslandserfahrungen zu sammeln.

Antike trifft auf...

...traumhafte Ausblicke!
Azubi-Starttag 2024
Herzlich Willkommen an der Universität Bremen!
Herzlich Willkommen liebe Azubis!
Am 10. Oktober durften wir unsere 22 neuen Auszubildenden an der Universität Bremen begrüßen.
Nach einem Grußwort von Konrektorin Mandy Boehnke haben sich die Azubis bei einem Frühstück gestärkt und hatten Zeit, sich kennenzulernen und auszutauschen.
Während der anschließenden Campus Tour konnten sich die Azubis dann einen großen Überblick über das Universitätsgelände verschaffen und hatten die Möglichkeit, in die angesiedelten Institute zu schnuppern.
Wir danken unseren Azubis für den schönen Tag und freuen uns, dass ihr da seid!

Unsere neuen Auszubildenden!
Unser Azubi-Grillen
Am 19. September hat wieder unser jährliches Azubi-Grillen im Sommer stattgefunden.
Gemeinsam haben wir einen schönen Abend mit vielen tollen Gesprächen, guter Musik und leckerem Essen verbracht.
Wir danken Gabi und Stine, unseren Auszubildenden zur Veranstaltungskauffrau, die unser Grillen wunderbar organisiert haben!

Beim Azubi-Grillen hatten unsere Azubis wieder die Möglichkeit, sich auszutauschen und Zeit miteinander zu verbringen.
Ausbildungskoordinatorin Silke Heinrich mit den beiden Organisatorinnen Gabi und Stine.

CSD Bremen 2024
Wir waren dabei!
Am 24. August wurde in Bremen der CSD gefeiert und die Universität Bremen war wieder mit ihrem eigenen Wagen dabei!
Gemeinsam mit unserer Kanzlerin Frauke Meyer, der Rektorin Jutta Günther und der Konrektorin Mandy Boehnke hatten wir einen bunten, lauten und tollen Tag und konnten unsere Message "University for Diversity - University of Diversity" verbreiten!
Wir freuen uns schon auf's nächste Jahr und hoffen, dass ihr auch wieder mit dabei seid!

Unser Uni-CSD Team 2024!

Kanzlerin Frauke Meyer, Rektorin Jutta Günther und Konrektorin Mandy Boehnke.

Unser Wagen - unser CSD Motto!
Erste Schritte im Labor
Die neuen Azubis im Biologie- und Chemiepraktikum
Mitte August war es endlich soweit: unsere neuen Auszubildenden zur Chemie- / Biologielaborant:in konnten ihre ersten praktischen Erfahrungen im Labor machen. Im Biologie- und Chemiepraktikum haben die Azubis ihre Schulkenntnisse vertieft und unter der Anleitung der Ausbilder:innen viele neue und interessante Eindrücke gesammelt.
Die Einführungspraktika werden unabhängig vom Ausbildungsziel jeweils in der Biologie und der Chemie abgeleistet; so können biochemische Zusammenhänge schnell verstanden werden.
Im Biologiepraktikum sind die Azubis der Frage nachgegangen, welche Bakterien sich in einem handelsüblichen Trinkjoghurt befinden, und ob es wirklich die sind, mit denen der Anbieter wirbt. Im Chemiepraktikum drehte sich alles um die Zitrone. Die Azubis haben herausgefunden, dass Zitronensaft nur 5-8% Zitronensäure enthält - viel weniger also, als gedacht.






Schülerinnen und Schüler in der Uni!
Am 09. August hatten wir die 9. Klasse der OS Schaumburger Straße im Rahmen ihrer Orientierungswoche bei uns zu Besuch.
Nachdem unsere Ausbildungskoordinatorin Silke Heinrich ihnen das Ausbildungsangebot der Uni Bremen vorgestellt und ihnen unseren Azubifilm gezeigt hat, ging es für die interessierten Schüler:innen zu unseren Werkstätten. Dort konnten sie sich in der Tischlerei selbst an der Werkbank ausprobieren, unseren Azubis der Betriebselektronik in der Ausbildungswerkstatt viele Fragen stellen und ihnen zuhören, wie sie von ihren ganz persönlichen Erfahrungen berichten.
Wir freuen uns über euren Besuch und hoffen, dass ihr einen spannenden Tag bei uns hattet

Nur zugucken? Fehlanzeige! Bei uns dürfen die Schülerinnen und Schüler sich selbst an der Werkbank ausprobieren.


Unsere Azubis der Betriebselektronik stellen sich den Fragen der Schülerinnen und Schüler.
Unsere Ausbildungsabsolventen 2024
Wir gratulieren zum erfolgreichen Ausbildungsabschluss!
In diesem Jahr haben 20 Auszubildende ihre Ausbildung an der Universität Bremen erfolgreich abgeschlossen. Mit Engagement, Teamgeist und Durchhaltevermögen konnten sie sich während ihrer Ausbildungszeit theoretisches Fachwissen aneignen und wertvolle praktische Erfahrungen sammeln, sodass sie nun bestens gerüstet sind, um in der Berufswelt voll durchzustarten!
Wir sind stolz darauf, mit euch diesen Meilenstein feiern zu können und freuen uns, eure weiteren beruflichen Schritte zu verfolgen. Wir wünschen euch alles Gute und viel Erfolg für eure Zukunft!
Wir gratulieren herzlich:
Milad Heidari
Robin Jacksteit
Mike Pister
Samhar Tomeh
Shiwan Wali
Frederic Brückmann
Bashar Harbi
Frederik Mathis Piel
Klemens Karbowski
Farhad Nouri
12.01.2024
12.01.2024
12.01.2024
12.01.2024
12.01.2024
13.01.2024
15.02.2024
15.02.2024
19.02.2024
28.02.2024
Swen Rengers
Jarnis König
Keno-Grace Bechtgold
Lea Berger
Kjell Naues
Lenoie Hiestermann
Lucas Petersen
Lukas Dirksen
Marco Anfres Feo Ziemann
Greta Melle
31.05.2024
10.06.2024
13.06.2024
13.06.2024
13.06.2024
14.06.2024
14.06.2024
20.06.2024
20.06.2024
20.06.2024
Absolventenfeier der Chemielaborant:innen
Am 20. Juni 2024 fand die Absolventenfeier unserer Chemielaborant:innen statt! Greta, Lukas und Marco haben ihre Ausbildung an der Universität Bremen erfolgreich abgeschlossen.
Die Absolventenfeier wurde von dem stolzen Labor-Ausbildungsteam für die Chemieabsolvent:innen unserer Uni und den Kooperationsfirmen ausgerichtet.




Ausbilder:innen Tina Zock, Peter Uhde und Ausbildungsleiter Peter Brackmann freuen sich über den erfolgreichen Ausbildungsabschluss der Chemielaborant:innen.
Breaking Secrets?! Unsere Exkursion zur Westfälischen Hochschule Recklinghausen
Gemeinsam mit unseren Ausbilder:innen waren die Azubis des Laborbereichs der Uni Bremen zu Besuch im Ruhrgebiet an der Westfälischen Hochschule in Recklinghausen.
Die Gastgeber Prof. Dr. Tausendfreund und Prof. Dr. Steinmann informierten nicht nur über das Studienangebot und die Forschung der Hochschule, sondern ermöglichten unseren Azubis außerdem einen aufregenden praxisbezogenen Ausflug in die Chemie: mit den modernen Analysegeräten des Labors für instrumentelle Analytik sollten sie die chemische Natur eines unbekannten, farblosen Kristallpulvers erforschen.
Wir bedanken uns nochmal ganz herzlich bei Prof. Dr. Tausendfreund und Prof. Dr. Steinmann für die Einblicke in ihr spannendes Forschungsgebiet und ihre Gastfreundschaft

Fotos: Westfälische Hochschule / Verena Roßa

Dr. Markus Steinmann zeigt unseren Azubis die Labore der Westfälischen Hochschule.
Der ISI 2024
Am 12. Juni fand der diesjährige ISI, der Informationstag für Studieninteressierte an Uni Bremen statt. Auch wir waren wieder mit dabei und haben unser Ausbildungsangebot vorgestellt.
Unser Auszubildender Umut aus der IT hat den Interessierten alles wichtige zum Bewerbungsverfahren und zum Ausbildungsablauf erzählt, Fragen beantwortet und ihnen auch seine ganz persönlichen Tipps und Highlights mit auf den Weg gegeben.

Unser Azubi Umut freut sich auf den Austausch mit den Interessierten.
Unser Besuch auf der Vocatium Messe 2024
Vom 29. bis zum 30. Mai waren wir bei der diesjährigen Vocatium Messe in Bremen und haben die Ausbildungsmöglichkeiten an der Uni Bremen vorgestellt. Unsere Auszubildenden hatten viele tolle Gespräche mit Interessierten, konnten Fragen klären und Einblicke in die verschiedenen Ausbildungen geben.


Informationstag für Studieninteressierte – Wir sind dabei!
Am 12. Juni 2024 findet an der Universität Bremen der ISI statt – der Informationstag für Studieninteressierte. Neben fachübergreifenden Info-Veranstaltungen und Vorstellungen der Studienangebote, verwandelt sich das Gebäude GW 2 an diesem Tag zu einer Infomesse. Von 9:00 bis 13:00 Uhr findet ihr hier Info Stände zu den Fächern und Service-Einrichtungen der Uni.
Auch wir möchten an unserem Stand mit euch in den Austausch gehen und eure Fragen über unsere Ausbildungsangebote und den Bewerbungsprozess beantworten. Kommt gerne vorbei, wir freuen uns auf euch!
Mehr Informationen und das gesamte Programm findet ihr hier: https://www.uni-bremen.de/isi
Vocatium 2024
Von Mittwoch, den 29.05. bis Donnerstag, den 30.05.2024 jeweils von 08:30-15:00 Uhr findet die Vocatium 2024 statt! Bei der Fachmesse für Ausbildung und Studium können Schüler*innen, Lehrkräfte, Eltern und weitere Studien- und Ausbildungsinteressierte mit Ausbildungsbetrieben und Universitäten ins Gespräch kommen und sich ein Bild von den verschiedenen Angeboten und Möglichkeiten machen.
Wir sind mit unserem Info- und Beratungsstand vor Ort und freuen uns, dass unsere Auszubildenen den Interessierten von ihren ganz persönlichen Erfahrungen berichten können.
Eindrücke vom "Markt der Berufe"
Am 18.04.2024 waren unsere Auszubildenden Ashley (Betriebselektronikerin), Mohammed (Betriebselektroniker), Alexandra (Tischlerin), Antonia (Informatikerin) Lars (Informatiker) mit unserer Ausbildungskoordinatorin Silke Heinrich zu Gast an der Oberschule an der Schaumburger Straße in Bremen. Auf dem „Markt der Berufe“ haben sie Schülerinnen und Schülern der 9. Klasse ihre Ausbildungen an der Universität Bremen vorgestellt.
Nach einer Präsentation von Silke Heinrich über die Uni als Ausbildungsort wurde den Schülerinnen und Schülern unser Film über die Ausbildung an der Uni Bremen gezeigt. Anschließend konnten unsere Auszubildenden von ihren ganz persönlichen Erfahrungen aus ihrer Ausbildung berichten und den Schülerinnen und Schülern ihre Fragen beantworten.
Wir freuen uns, dass wir dem 9. Jahrgang der Oberschule an der Schaumburger Straße auch in diesem Jahr mit unserem Besuch Einblicke in die Ausbildungswelt der Universität Bremen geben konnten!

Mohammed und Ashley zeigen den Schülerinnen und Schülern praktische Beispiele aus der Betriebselektronik.


Lars und Antonia stehen den Schülerinnen und Schülern Rede und Antwort über ihre Ausbildung der Informatik.


Alexandra erzählt von ihrer Ausbildung in der Tischlerei.

„Aware together“ – Uni Aktionstag gegen Diskriminierung
Am Mittwoch, den 24. April lädt die Universität zum ersten Uni-Aktionstag gegen Diskriminierung ein!
Mit Workshops, Informationsständen und verschiedenen Aktionen zu den Themen Diversität und Diskriminierung sollen auf den Campus offene Räume für Reflexion, Diskussion und Begegnungen entstehen. Das Angebot ist groß: ob „Diversity to go“ in den Fahrstühlen des GW2s, ein Empowerment-Impuls für BlPoC Studierende oder eine Diskussion zur Diskriminierung in künstlicher Intelligenz – hier ist für jede*n etwas Spannendes dabei. Das umfangreiche Programm findet ihr hier.
Institutsführung 2024
Während der Institutsführung im Februar hatten unsere Azubis die Möglichkeit spannende Einblicke in die verschiedenen Forschungsbereiche der Universität Bremen zu gewinnen. Gestartet haben wir um 8:30 Uhr vor dem Verwaltungsgebäude. Von dort ging es gemeinsam zu Fuß zum Deutschen Zentrum für Luft- und Raumfahrt (DLR), wo wir uns einen großen Überblick über die Laborflächen verschaffen konnten und spannende Informationen zur Weltraumforschung erfahren haben. Am ZARM, dem Zentrum für angewandte Raumfahrttechnologie und Mikrogravitation, leicht zu erkennen am einzigartigen Fallturm, drehte sich alles um die Forschungen in den Bereichen Strömungsmechanik, Weltraumwissenschaften und Raumfahrttechnologien. Weiter ging es zum Zentrum für Technomathematik, dem ZeTeM, unter anderem eine Entwicklungsstelle für autonome Fahrzeuge. Diese konnten wir nicht nur hautnah begutachten, sondern auch in Aktion erleben. Unsere Tour endete um 12 Uhr bei einem gemeinsamen Mittagessen in der Mensa.

Unsere Auszubildenden vor dem Fallturm des ZARM, dem Zentrum für angewandte Raumfahrttechnologie und Mikrogravitation.

Auf der Teststrecke des Zentrums für Technomathematik.

Im ZeTeM konnten wir die Forschung von autonomer Technologie in der Praxis erleben.
Azubi-Starttag 2023
Wir wünschen unseren neue Azubis einen guten Start in die Ausbildung und eine schöne Zeit an der Universität Bremen.
Nach den Begrüßungsworten von Frauke Meyer, der Kanzlerin der Uni und einem gemeinsamen Frühstück ging es los zu einem Rundgang über den Campus.
Ich habe mich sehr gefreut, die neuen Azubis kennenzulernen.
Alles Gute für euch!
Silke






Christopher Street Day 2023
Am 26. August fand der Christopher Street Day (CSD) in Bremen statt und erstmals war die Uni Bremen mit eigenem Truck und Musik aktiver Bestandteil des Umzugs. Zusammen haben wir ein Zeichen für Vielfalt, Gleichberechtigung und Akzeptanz gesetzt.
Auch als Ausbildungsort setzen wir uns für Chancengleichheit, Diversität, Inklusion und vieles mehr ein, indem wir alle Menschen unabhängig von Herkunft, Religion, Weltanschauung, Alter, Behinderung oder sexueller und geschlechtlicher Identität willkommen heißen!
Hier findet ihr ein paar Eindrücke zum diesjährigen CSD in Bremen!
University for Diversity !
Viele Grüße
Silke (Heinrich)



Open Campus | Welten öffnen - Wissen teilen!
Zielsicher in die berufliche Zukunft - Unser Motto in unserem Ausbildungs-Café auf dem Open Campus.
Ein Gespräch, ein kühles Getränk oder ein Kaffee mit Gebäck?
Luis, Tayfun, Sascha, Henri und Leonid haben trotz Hitze mit viel Engagement alle Ausbildungsbereiche der Uni Bremen vertreten.
Im Rahmen der vocatium Bremen 2023 erwarteten uns viele Beratungsgespräche
Die vocatium Bremen öffnete am 14. und 15. Juni 2023 erneut ihre Tore bei der MESSE BREMEN und hat Schülerinnen und Schüler, Eltern sowie Lehrkräfte eingeladen, sich umfassend über die vielfältigen Möglichkeiten der beruflichen Bildung und Orientierung zu informieren.
Anna, Finn, Grace und Bahar haben alle die beraten, die sich für eine Ausbildung zur/zum Biologie- oder Chemielaborant:in interessierten.
Informationstag für Studien- und Ausbildungsinteressierte - Wir waren dabei
Erstmals haben wir am Informationstag für Studieninteressierte unser Ausbildungsangebot präsentieren können.
Luis stand zur Beratung an unserem Info-Stand zur Verfügung und Peter Brackmann hat mit Finn einen Vortrag über die Ausbildungsmöglichkeiten an der Uni am Beispiel der Ausbildung im Laborbereich gehalten.
Ein guter Auftakt für das nächste Jahr.
Besucht uns im Ausbildungs-Café in der Pagode Nr. 3
Unser Ausbildungs-Café in der Pagode Nummer 3 bietet die Gelegenheit, sich über unser Ausbildungsangebot zu informieren. Auszubildende aus unterschiedlichen Bereichen und die Ausbildungskoordinatorin Silke Heinrich laden herzlich zu einem Gespräch und einem kühlen Getränk ein.
Wer sich gern vorab informieren möchte: Hier geht es zur Ausbildungsstartseite der Universität www.uni-bremen.de/ausbildung
wir freuen uns auf euch!
Studieren oder eine Ausbildung absolvieren? Besuche uns am Informationstag für Studieninteressierte (plus Ausbildung) 10. Mai 2023
Bist du dir noch nicht sicher, welchen Weg du gehen möchtest? Wir helfen dir gern bei deiner Entscheidung.
Die Universität Bremen ist nicht nur Ausbildungsort für Studierende und Nachwuchswissenschaftler:innen, sondern bildet jährlich auch ca. 80 junge Menschen in verschiedenen Ausbildungsberufen aus. Das Ausbildungsangebot der Uni Bremen erstreckt sich von handwerklich und technisch orientierten Berufen über Laborberufe bis zu dienstleistenden Tätigkeiten. Weitere Informationen sind über diesen Link zu finden: www.uni-bremen.de/ausbildung. Der Info-Stand bietet die Gelegenheit, sich über das Ausbildungsangebot an der Universität Bremen zu informieren und sich direkt mit Auszubildenden auszutauschen.
Mittwoch, 10.05.2023, 09:00 Uhr bis 13:00 Uhr, Raum: GW2 Treppenhaus
Oder schau beim Vortrag vorbei:
In dieser Veranstaltung wird über die Ausbildungsmöglichkeiten, -inhalte und –abläufe und Bewerbungsverfahren berichtet. Peter Brackmann, Ausbildungsleiter aus dem Laborbereich informiert über diese Themen exemplarisch anhand der Ausbildungsberufe Biologielaborant:in und Chemielaborant:in. Fragen werden gern beantwortet.
Termine:
Mittwoch, 10.05.2023, 08:30 Uhr bis 09:15 Uhr, Raum: SFG 0150
BIB - Berufsinformationsbörse 2023
Das Angebot der Beruf-Informations-Börse, richtet sich insbesondere an Schüler:innen der Abschlussklassen der verschiedenen Schulen aus der Region um Syke. Das sind u.a. die Klassen 8 bis 10 sowie die Jahrgänge 11 bis 13. Wir waren dabei!

Luis berichtet über die vielfältigen Ausbildungsmöglichkeiten an der Uni Bremen.
Institutsführung für unsere Auszubildenden von unseren Auszubildenden
Unsere Auszubildenden Stine und Gabi haben eine spannende Institutsführung für unsere Auszubildende organisiert.
Abschließend gab es Mittagessen in der Mensa.
Im Zentrum für Technomathematik: Das Ziel von AO-Car ist die Entwicklung von autonomen und optimalen und damit sicheren Fahrmanövern für (Elektro-)Autos im Stadtverkehr.

Matthias Knauer berichtet über das System zur Analysierung von Verkehrszeichen für das autonome Fahren.
Im Zentrum für Technomathematik konnten die Azubis eine Simulation beobachten, welche wichtig für die Forschung im Bereich Flugzeugtechnologie ist.
Im Deutschen Forschungszentrum für Künstliche Intelligenz: B-Human ist zurzeit eines der besten Teams in der RoboCup Standard Platform League und hat neunmal die Weltmeisterschaft sowie zwölf regionale Wettbewerbe gewonnen.
Im Forschungszentrum MARUM – Zentrum für Marine Umweltwissenschaften: In der Werkstatt dieses Instituts werden die Roboter instand gesetzt. Diese entnehmen dem Meeresboden Bodenproben. Die Proben werden im größten Bohrkernlager weltweit für Forschungszwecke gelagert.
Herzlichen Glückwunsch an unsere Ausbildungsabsolventen 2022
Wir freuen uns für euch!
David Bucheli Paula Barein Luise Brandt Rico Schulze Marlo Wünsch Jonas Nordwich Mohammed Amin Wali Kevin Glubiak Jonathan Knief Julia Böttjer Noomi Kublenz Shadi Yaghoub Norogini Balamuraly
|
13.07.2022 24.01.2022 24.01.2022 24.01.2022 07.07.2022 07.07.2022
11.02.2022 11.02.2022 28.02.2022 20.06.2022 15.06.2022
|
Nathan Palme Kevin Joris Holm Tom Schiebenhöfer Jakob Onesseit Bennet Petznik Marcel Kwetschlich Filmon Awot Bennet Gründel Samantha Vogel Pauline von Oehsen |
16.06.2022 27.01.2022 23.06.2022 16.01.2022 23.06.2022 15.06.2022 14.01.2022 17.06.2022 27.06.2022 16.06.2022 |
Azubi-Starttag 2022
Auch in in diesem Jahr hat die Kanzlerin Frauke Meyer die neuen Auszubildenden begrüßt.
Bei einem leckeren Frühstück konnten sich die neuen Azubis untereinander kennenlernen.
Auf der anschließenden Campus-Tour wurden alle mit wichtigen Informationen rund um die Uni versorgt.
Alles Gute und eine schöne Zeit wünscht euch das Ausbildungsteam der Universität Bremen.
job4you in Oldenburg
Auf der job4you in Oldenburg haben wir die Universität Bremen gemeinsam mit Unternehmen aus dem Technologiepark präsentiert.
Das Uni-Fest für Auszubildende und Mitarbeitende
Die Universitätsleitung hat zum 50jährigen Universitätsjubiläum und als Dankeschön für die Flexibilität, das Verständnis und die Umsicht in der Pandemie zu einem Fest eingeladen.
Auszubildende und Mitarbeitende haben auf dem Uni-Gelände geschnackt, gelacht und getanzt. In der Fotobox und am Kicker war ständig was los und auch die Bars und Food-Stände waren sehr beliebt. Die gute Stimmung hielt bis nachts an und wir hoffen auf eine Wiederholung.
Vocatium Bremen 2022 – Wir waren dabei!
Ausbildungsberufe und Studiengänge kennenlernen. Dazu persönliche Gespräche mit unseren Auszubildenden führen. Das war an zwei Tagen im Juni am Uni-Stand auf der Vocatium möglich. Grace und Lea haben über 80 Schüler:innen Fragen beantwortet und über ihre Ausbildung im Ausbildungszentrum für Laborant:innen berichtet.
Markt der Berufe in der Oberschule an der Schaumburger Straße
Am 19.05.2022 haben wir am Markt der Berufe in der Oberschule an der Schaumburger Straße teilgenommen. Dort konnten die Schüler:innen unsere Ausbildungsbereiche Informatik, Betriebselektronik und Labor kennenlernen.
Berufsparcours in der Oberschule am Waller Ring
Im November 2021 haben wir uns am Berufsparcours in der Oberschule am Waller Ring beteiligt.
Durch den Einsatz unserer Azubis aus den Bereichen Labor, Tischlerei und Betriebselektronik konnten sich mehrere hundert Schüler:innen von drei Oberschulen an zwei Tagen in den Berufen ausprobieren und sich informieren.
Azubi-Starttag 2021
Begrüßung aller neuen Auszubildenden
Am 20. Oktober 2021 wurden mit dem Azubi-Starttag die neuen Azubis des Jahrgangs 2021 begrüßt. Schön, dass ihr dabei seid!
Nach der Begrüßung der Kanzlerin und einem gemeinsamen Frühstück ging es los zur Campusführung. Die Studienlotsinnen der Uni Bremen haben den neuen Azubis nicht nur den Campus gezeigt, sondern auch mit Informationen zur Universität versorgt.
Wir wünschen allen neuen Azubis eine erfolgreiche Ausbildung und eine schöne Zeit an der Uni Bremen!
Einblicke und Erfahrungsberichte
Hier berichten unsere Azubis und ehemaligen Azubis aus den Ausbildungsbereichen:

Anastasia (19) absolviert gerade eine Ausbildung zur Biologielaborantin an der Universität in Bremen. Im September 2021 startete sie ins 2. Ausbildungsjahr und schildert hier ihre Eindrücke:
Das erste Lehrjahr als Biologielaborantin verging wie im Flug. Als ich vor dem Abitur stand, fiel mir die Wahl für meine berufliche Laufbahn recht leicht. Biologie ist meine Leidenschaft. Wenn man nicht unbedingt studieren möchte, bietet der Ausbildungsberuf Biologielaborant:in eine fabelhafte Möglichkeit sein naturwissenschaftliches Interesse zu fördern.
Der Bewerbungsprozess an der Universität Bremen lief wie folgt ab:
Nachdem ich mein Bewerbungsschreiben inklusive Lebenslauf, das letzte Halbjahreszeugnis und die Bestätigungen meiner Praktika eingereicht hatte, bekam ich eine Mail und wurde zu einem schriftlichen Einstellungstest eingeladen. Dieser wurde (vor Corona) in einem großen Hörsaal mit vielen anderen Bewerber:innen geschrieben. Das Tolle daran: es wird allen eine Chance gegeben, diesen Test zu absolvieren! Ein paar Wochen später wurde ich zu einem Vorstellungsgespräch mit integriertem Praxisteil eingeladen. Hierbei war besonders, dass man ebenfalls mit mehreren Bewerber:innen in einem Raum saß. Bei lockerer Atmosphäre stellten sich alle vor und erzählten etwas über sich. Danach bekamen wir im Labor ein paar Aufgaben, wie zum Beispiel das Pipettieren. Das war eine schöne Gelegenheit, sich selbst zu testen und den Umgang mit den Geräten zu üben. Im Anschluss hatten wir die Möglichkeit mit den Auszubildenden aus den höheren Lehrjahren zu quatschen und Fragen zu stellen. Kurz und knapp: Das Bewerbungsverfahren war angenehm und nebenbei eine tolle Chance um herauszufinden, ob dieser Beruf zu mir passt.
Im September 2020 startete ich mit 3 anderen Auszubildenden aus der Biologie und 3 aus der Chemie meine Ausbildung. Mit Maskenpflicht, Abständen und Desinfizieren erlernten wir in 2 Monaten Grundlagenpraktikum die wichtigsten Techniken und den Umgang mit Laborutensilien. Auch dies war ein Erfolgserlebnis, da man innerhalb kürzester Zeit viel lernte und diese Dinge sofort in der Praxis anwenden konnte.
Im November wurden wir unterschiedlichen Arbeitsgruppen auf dem Campus zugeteilt. Die Arbeitsgruppen wechseln wir ca. alle 6 Monate, je nachdem, wie es inhaltlich und zeitlich passt. Dazwischen finden zur Vermittlung und Vertiefung spezieller Ausbildungsinhalte und zur Vorbereitung auf den 1. und 2. Teil der Abschlussprüfung verschiedene Praktika im Ausbildungslabor statt.
In den Arbeitsgruppen werden wir meistens von ausgelernten Technische Assistent:innen oder Doktorand:innen betreut. Man wird in den Laboralltag integriert und übernimmt meist nach kurzer Zeit ganze Aufgaben allein. Dabei wird sichergestellt, dass man genau weiß, wie man was machen muss. Und egal wie oft man schon gefragt hat, es gilt: Wenn du dir nicht sicher bist, frag nochmal! Dann wird es einem nochmal erklärt oder man führt die Tätigkeit mit Hilfe bzw. unter Aufsicht durch.
Umso sicherer man wird, desto mehr Aufgaben werden einem allein zugetraut, sodass man sogar die Chance auf eigene kleine Mini-Projekte innerhalb der AG hat.
In die Berufsschule geht man 2 Tage die Woche, die restlichen 3 Tage ist man arbeiten. Im Unterricht werden unterschiedliche Lernfelder erarbeitet, um das fachspezifische Wissen zu erlangen. Außerdem werden Sport, Politik, Deutsch und Englisch unterrichtet.
Die Auszubildenden der Universität im Fachbereich Biologie und Chemie treffen sich einmal die Woche zur Lernstunde. Dabei kann man Fragen zum Lernstoff stellen und bestimmte Themen nochmal verfestigen. Das Lernen in der Gruppe ist dafür eine tolle Möglichkeit, weil alle dazu beitragen können und es natürlich mehr Spaß macht.
Wir können unsere Ausbilder:innen jederzeit erreichen, wenn wir Fragen, Sorgen und Nöte haben.
Julia (22) absolviert gerade eine Ausbildung zur Fachangestellten für Medien- und Informationsdienste, Fachrichtung Bibliothek in der Staats- und Universitätsbibliothek der Universität Bremen. Hier kannst du ihren Bericht über ihre Ausbildung lesen.
Durch meinen Bundesfreiwilligendienst in der Stadtbibliothek Schwerin, wurde bei mir das Interesse für diese Ausbildung geweckt, sodass ich mich schnellstmöglich für den Beruf deutschlandweit beworben hatte. Am Ende jedoch entschied ich mich für die Fachrichtung Bibliothek und startete meine Ausbildung in der wissenschaftlichen Bibliothek in Bremen.
Bei der Ausbildung zu Fachangestellten für Informationsdienste – genannt FAMI - entscheidet man sich nicht nur für den Betrieb, sondern wählt auch eine der fünf Fachrichtungen aus.
Zu diesen Fachrichtungen zählen:
- Archiv
- Bildagentur
- Bibliothek (ÖB/WB)
- Information und Dokumentation
- Medizinische Dokumentation
Während der Ausbildung in der Staats- und Universitätsbibliothek Bremen durchläuft man viele Abteilungen des Hauses und bekommt einen Einblick in die Vielfältigkeit der Aufgaben des Berufes und wird täglich aufs Neue gefördert. Zudem hat man die Möglichkeit ein Archiv, die Teilbibliotheken der Staats- und Universitätsbibliothek und die Stadtbibliothek in Bremen kennenzulernen.
In der Ausbildung ist man wöchentlich zwei Tage in der Berufsschule Schulzentrum Utbremen und drei Tage im Betrieb.
In der Berufsschule wird den Auszubildenden das Beschaffen, Erschließen, Vermitteln und Bereitstellen von Medien, Informationen und Daten sowie die Beratung und Betreuung von Kunden und Kundinnen nähergebracht, was wiederrum im Betrieb gefestigt wird.
Gegen Ende der Ausbildung steht in der Staats- und Universitätsbibliothek die Abteilung „Infoteam“ an. Dort kommen Auszubildende wieder viel mit Kunden und Kundinnen in Kontakt und werden dadurch sehr gut auf die praktische Abschlussprüfung vorbereitet.
Wenn ich euch für den Beruf „Fachangestellte/r für Medien und Informationsdienste, Fachrichtung Bibliothek" begeistern konnte, dann schaut doch gerne mal bei Bibgebabbel, dem FaMI-Ausbildungsblog, vorbei. Dort findet Ihr nochmal viele Informationen was euch in der Staats- und Universitätsbibliothek erwartet.
Nathan ist Auszubildender im dritten Lehrjahr. Im Fachbereich 3 (Mathematik und Informatik) ist er als Fachinformatiker für Systemintegration tätig. Wie ist es ihm bisher in seiner Ausbildung ergangen?
Durch eine gute Bekannte bin ich auf die Universität Bremen als Ausbildungsbetrieb aufmerksam geworden. Da ich bereits eine schulische Ausbildung (Informationstechnischer Assistent) hinter mir habe, war das Interesse geweckt. Daher habe ich mich für die Ausbildung an der Universität Bremen als Fachinformatiker im Bereich Systemintegration beworben.
Bevor ihr überhaupt in das Bewerbungsgespräch kommt, werdet ihr getestet. Hierfür ist es egal, welche Vorerfahrungen ihr gemacht habt. Die meisten Themen bekommt ihr vorher mitgeteilt, wodurch ihr euch gut vorbereiten könnt. Beim erfolgreichen Absolvieren des Testes werdet ihr zum Bewerbungsgespräch eingeladen. Vor dem Gespräch gibt es die Möglichkeit, mit den anderen Auszubildenden zu reden und hier auch schon erste Eindrücke zu gewinnen. Die Ausbilder:innen aus dem Bereich Fachinformatik begrüßen euch anschließend und eine Fragerunde beginnt. Natürlich sind auch hier Gegenfragen gewünscht und gewollt. Es folgt im Anschluss ein praktischer Teil, der ebenso im Bereich Informatik stattfindet, um die Kenntnisse festzustellen. Bei mir wurde ein PC zur Verfügung gestellt, welcher dann erklärt werden sollte. Alles in einem bekommt man einen guten Eindruck und die Ausbilder:innen bemerken auch vorhandene Kenntnisse an. Solltet ihr auch diese Etappe gemeistert haben, seid ihr auch schon Teil des Auszubildenden-Teams an der Universität Bremen.
In der Berufsschule, welche für das erste Lehrjahr und zweite Lehrjahr 2 Berufsschultage vorsieht und für das dritte Lehrjahr 1 Tag, lernt ihr alle wichtigen Kenntnisse. Von Grundkenntnissen wie „die Komponenten eines PC" bis hin zu Datenbanken und Wirtschaftswesen. Hierzu werdet ihr in Lernfeldern unterrichtet. Die folgenden Lernfelder habt ihr dann:
- Wirtschaft
- Informatik-Systeme
- Informatik-Sicherheit
- Python Programmierung/Skripting
- Serviceleistungen
- Datenbanken
- Elektrotechnik
- Englisch
- Politik
Diese Lernfelder wechseln sich dann in den Wochen ab, sodass ihr von allem etwas habt. Gegen Mitte der Ausbildungszeit stehen dann die Zwischenprüfung und ein Projekt an, das sogenannte Mittelstufenprojekt. Die Zwischenprüfung soll euch ein Gefühl für die Abschlussprüfung geben und das Mittelstufenprojekt für das am Ende anstehende Abschlussprojekt. Für das Abschlussprojekt bekommt ihr an der Universität Bremen eine vollumfassende Betreuung.
Das Arbeiten an der Universität Bremen ist sehr entspannt. Ihr arbeitet an Forschungsprojekten und gestaltet diese durch eure Arbeit mit. Ihr sorgt auch mit euren Ausbilder:innen für eine reibungslose Informatik-Infrastruktur. Das heißt, ihr verwaltet und betreut ganze Arbeitsgruppen, macht Beschaffungen für Mitarbeiter, richtet Geräte ein und noch vieles mehr.
An der Universität Bremen zu arbeiten, ist etwas ganz Besonderes. Ihr habt hier die Möglichkeit, eine wirkliche gute Ausbildung abzuschließen, die euch in der Berufswelt viel weiterhelfen kann. Bei bestandener Prüfung seid ihr offiziell ausgelernte Fachinformatiker. Und könnt eventuell an der Universität Bremen übernommen werden, was ebenso super ist. Parkmöglichkeiten und eine direkte Bahnanbindung sorgen für Mobilität. Und bei einem Mittagessen in der Universitätseigenen Mensa könnt ihr euch mit euren Azubi-Kolleg:innen auch über alle anderen Sachen unterhalten. Bei Fragen und Problemen stehen euch die Ausbilder zur Seite, auch bei ausbildungsfremden Angelegenheiten.
Also ich hoffe, ich habe euch für den Beruf „Fachinformatiker:in Systemintegration" begeistern können. Mehr Informationen findet ihr hier auf https://www.uni-bremen.de/ausbildung oder auch auf der Seite „Ausbildung am Fachbereich 3".
Bashar (21) absolviert gerade eine Ausbildung als Biologielaborant an der Universität Bremen. Er befindet aktuell im 2. Ausbildungsjahr und berichtet hier von seinen Eindrücken und dem Bewerbungsprozess.
Durch mein einjähriges Praktikum im Labor an der Universität Bremen wurde bei mir das Interesse für die Ausbildung zum Biologielaboranten geweckt. Daher habe ich mich für die Ausbildung an der Universität Bremen beworben.
Zu Beginn unserer Ausbildung haben wir ein mehrwöchiges Grundlagenpraktikum bei unseren Ausbilder:innen im Ausbildungszentrum erhalten, in dem wir verschiedene Arbeitstechniken erlernen. Über die Ausbildungszeit verteilt haben wir mehrere Praktika. Während der Ausbildung an der Universität Bremen arbeitet man in unterschiedlichen Arbeitsgruppen und bekommt einen Einblick in die Vielfältigkeit der Aufgaben des Berufes. Die Arbeitsgruppen wechseln wir ca.. alle 6 Monate. In den Arbeitsgruppen werden wir von Technischen Assistent:innen oder Doktorand:innen betreut. Beim Wechsel in die neue AG bekommt man eine entsprechende Sicherheitseinweisung. Die Technischen Assistent:innen weisen uns in die Arbeiten ein, die wir später selbstständig durchführen dürfen. Für Fragen stehen uns die Technischen Assistent:innen und die gesamte Arbeitsgruppe immer hilfreich zur Seite.
In der Ausbildung ist man an zwei Tagen in der Berufsschule (Schulzentrum Utbremen) und 3 Tage in Universität. In der Berufsschule werden verschiedene Lernfelder unterrichtet, zum Beispiel Mikrobiologie, Chemie, Chromatographie, Mathe, Hämatologie, Politik und Englisch.
Einmal wöchentlich erhalten wir eine zusätzliche Lernstunde im Ausbildungszentrum. Wir können unsere Ausbilder immer erreichen, zum Beispiel, wenn wir Fragen oder Sorgen haben sind sie unsere Ansprechpersonen.
Wenn ich euch für den Beruf ,,Biologielaborant:in" begeistern konnte, dann schaut gerne mal auf der Seite ,,Ausbildungszentrum für Laboranten - Universität Bremen“ nach. Dort habt ihr die Möglichkeit, mehr Informationen zu diesem Beruf zu erhalten.
Ehemaliger Azubi Victor hat 2011 seine Ausbildung zum Fachinformatiker mit der Fachrichtung Systemintegration an der Universität Bremen absolviert. Derzeit ist er an der Uni als Informatiker angestellt und bildet selbst Azubis aus. Hier sein Erfahrungsbericht:
Schon früh in der Ausbildung an der Universität Bremen habe ich erkannt, dass dies kein normaler Ausbildungsbetrieb ist. Die Ausbildung an der Universität ist geprägt von wissenschaftlicher Arbeit. Auszubildende arbeiten an modernsten PC- und Serversystemen und kein Arbeitstag gleicht dem anderen. Während meiner zweineinhalbjährigen Ausbildung im Fachbereich 3 wurde viel Wert auf selbstständige Arbeit gelegt, bei der ich nach gut drei Monate Informatik-Grundkurs mein Können unter Beweis stellen konnte. Ob Mail- oder Datenserver, GPU-Clusterr oder Netzwerkhardware - an der Uni ist so ziemlich alles vertreten, was einen Daten- und Stromanschluss hat. Und so konnte ich mir dank abwechslungsreicher Ausbildungstätigkeiten ein umfangreiches Repertoire an Informatik-Kenntnissen aneignen, welches mir in meiner beruflichen Laufbahn als Systemadministrator alle Tore und Türen geöffnet hat.
Vor allem die Arbeit in wissenschaftlichen Forschungsprojekten war ein Highlight meiner Ausbildung. Professoren und Wissenschaftler stellen zum Teil hohe Anforderungen an die technische Ausstattung ihrer Projekte, sodass deren Betreuung alles andere als langweilig war. Und dabei genießt man als Auszubildender an der Universität Bremen alle Vorzüge des öffentlichen Dienstes.
Joris (24) absolviert gerade eine Ausbildung zum Fachinformatiker Fachrichtung Systemintegration bei der Universität Bremen. Er ist aktuell im 3. Lehrjahr und berichtet hier von seinen Eindrücken.
Die Arbeit mit Computern hat mir schon immer Spaß gemacht. Daher stand für mich schon lange fest, dass ich einen Beruf in der Informatik machen werde. Im ersten Anlauf habe ich es mit einem Informatikstudium versucht. Leider war das Informatikstudium viel theoretischer als ich gehofft hatte, und so habe ich mich nach einer praxisnäheren Option umgeschaut. Ich habe dann die Ausbildung zum Fachinformatiker Fachrichtung Systemintegration bei einem kleinen Informatik-Dienstleister in Bremen begonnen. Allerdings war dieser Informatik-Dienstleister leider kein guter Ausbildungsbetrieb, weshalb ich mich mithilfe der Industrie- und Handelskammer nach einem anderen Ausbildungsbetrieb umgeschaut habe. Bei der Universität Bremen konnte ich so nahtlos meine bereits begonnene Ausbildung fortsetzen.
Bei der Universität Bremen bin ich jetzt im Fachbereich der Mathematik und Informatik und arbeite an wissenschaftlichen Projekten mit. Eins der Forschungsprojekte, bei dem ich von technischer Seite unterstütze, nennt sich OPA³L. In dem Projekt wird eine autonome Fahrzeugsteuerung entwickelt. In dem Projekt unterstütze ich dabei, Geräte zur V2X Kommunikation zwischen Fahrzeugen zu integrieren. Ein zweites Projekt, in dem ich mitarbeite, nennt sich SmartFarm2. In dem Projekt werden Stromverbrauch und die Stromerzeugung an verschiedenen Standorten gemessen und von Wissenschaftlern analysiert. Für das Projekt wurde von uns Azubis ein Server mit selbst ausgewählter Software zum Sammeln der Messdaten aufgesetzt und in den Produktivbetrieb aufgenommen. Auch arbeite ich daran, die Datenübertragung bei den verschiedenen Standorten mithilfe von LoRa-Funkdatenübertragung zu ermöglichen.
Ein weiterer großer Vorteil der Ausbildung bei der Universität Bremen ist, dass man wirklich sehr gut auf das Abschlussprojekt und die Präsentation, die dazu gehört, vorbereitet wird. Für Fragen stehen immer die Ausbilder:innen zur Verfügung und wenn Zeit zum Lernen benötigt wird, wird immer eine Lösung gefunden. Wo ich von Mitschülern in der Berufsschule schon gehört habe, dass für das Abschlussprojekt neben den normalen täglichen Aufgaben fast keine Zeit bleibt, wird einem bei der Universität Bremen dafür genug Zeit gegeben. Präsentieren wird ab Beginn der Ausbildung regelmäßig mit kleinen Vorträgen geübt und auch die Abschlusspräsentation kann den Ausbildern so oft vorgetragen werden, bis diese die auswendig mitsprechen können.
Wie man sieht, entspricht die Ausbildung bei der Universität Bremen nicht dem Standard von nur Passwörter für andere Mitarbeiter zurücksetzen und immer wieder die gleiche Software installieren. Die Ausbildung hier hat die Möglichkeit, deutlich abwechslungsreicher zu sein, wenn man selbst die Motivation dafür mitbringt.
Reinschauen und -hören
Der Azubi-Podcast
Von der Schule zur Uni
Im Podcast erklären Amelie und Anastasia alles rund um eine Berufsausbildung an der Uni Bremen. Außerdem erzählen die beiden von ihrem Ausbildungsalltag als Laborantinnen.






































































